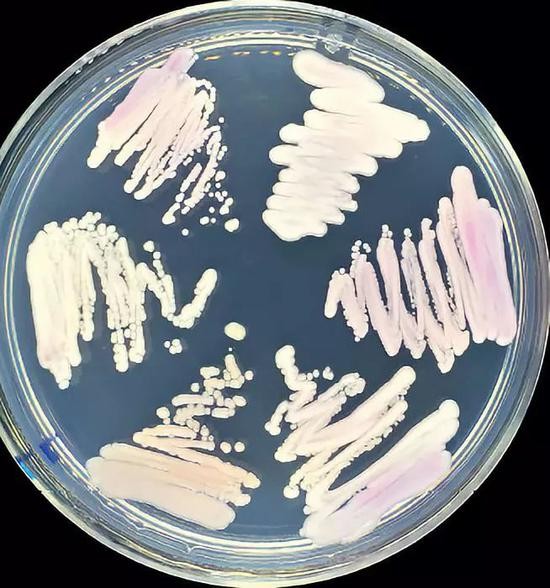
上海市医学真菌分子生物学重点实验室用科马嘉念珠菌显色培养基鉴定国内外耳念珠菌，均呈现出粉色。也有研究表示，耳念珠菌在培养基中会呈现白色，这主要与不同耳念珠菌菌株特征或培养基的染色剂有关。图/受访者提供

上海市医学真菌分子生物学重点实验室用科马嘉念珠菌显色培养基鉴定国内外耳念珠菌,均呈现出粉色。也有研究表示,耳念珠菌在培养基中会呈现白色,这主要与不同耳念珠菌菌株特征或培养基的染色剂有关。图/受访者提供
“超级真菌”来袭
去年4月5日,北京某医院新生儿重症监护室收治了一名刚出生71天的婴儿,这个出生时不到1公斤的早产儿被败血症、贫血、低血糖、高痉挛等多种疾病折磨。21天后,另一名刚出生的早产儿也被送到了同一重症监护室,后者出现了呼吸困难并逐渐加重等症状。
医生在两名婴儿的血液样本中发现了同一种“新型”病原真菌“耳念珠菌”。因其对一种或多种抗真菌药物具有耐药性和高达60%的死亡率,耳念珠菌又被称为“超级真菌”,它以免疫系统薄弱的人为猎物,已经蔓延到全球30多个国家和地区。
美国《纽约时报》4月6日报道,纽约市西奈山医院去年5月为一名老年男子做腹部手术时,发现他感染了耳念珠菌。老人最终在重症监护室隔离90天后死亡,而这种致命真菌却顽强地存活下来,并占领了整个病房,院方为此对墙壁、病床、门、水槽、电话都进行了特殊消毒,甚至拆除了部分天花板和地板。
据美国疾病控制与预防中心(CDC)追踪,截至今年3月29日,耳念珠菌已经在纽约、新泽西和伊利诺伊等12个州出现爆发性流行,感染病例上升到587宗,近50%的感染者在90天内身亡。
幸运的是,中国两名感染耳念珠菌的新生儿在治疗1~2个月后均治愈出院。“截至目前,中国已确认18例超级真菌临床感染病例,我们还在持续监测,但总体上还没有发现美国那样的爆发性流行感染。”中国工程院院士、上海市医学真菌分子生物学重点实验室主任廖万清告诉《中国新闻周刊》。
“超级真菌”现身中国
“超级真菌能长时间存活于患者和医护人员的皮肤及医院设施表面,若感染控制措施不力,容易导致院内爆发性感染。”北京大学医学部检验学系主任、北京大学人民医院检验科主任王辉说。她与中科院微生物研究所真菌学国家重点实验室研究员黄广华分别率领团队,共同发现了中国首例耳念珠菌临床感染病例。
黄广华现任上海复旦大学生命科学学院特聘教授。2018年1月,当他得知王辉在一位76岁患者身上分离到耳念珠菌后,马上与王辉取得联系,两人分工合作,整个春节都在加班。4个月后,两人联合在国际期刊《新发病原体及感染》上报道了中国首株耳念珠菌。
耳念珠菌在标准科马嘉培养皿中,呈白色或粉色,表面像乳液一样光滑。这种超级真菌的部分分离株对临床上常用的三大类抗真菌药物(唑类、多烯类和棘白霉素类)具有很高的耐药性。美国疾病控制与预防中心总结的数据是,90%以上的分离株对一种抗真菌药物耐药,至少30%的菌株对两类以上药物具有耐受性。
与其他国家报道的多重耐药性不同,中国首株耳念珠菌对临床常用抗真菌药物均较为敏感。然而,在后续实验中,当研究人员用氟康唑等一线抗真菌药物持续作用48小时或更久,便会诱导出耳念珠菌的耐药性。“真菌在不断进化,适应新的环境,它们的进化速度要比人快得多。”黄广华对《中国新闻周刊》说。
由于常规的消毒剂很难将耳念珠菌从医疗器械表面清除,黄广华团队还研究了其他消毒用化学试剂,并发现硫酸铜对超级真菌具有很强的生长抑制作用,这为医院内感染防治、清除耳念珠菌提供了新途径。
王辉团队在发现首例临床感染后,马上对患者进行了床旁隔离,并全程监测,并未在患者周围环境检测到新的感染。黄广华还对真菌形态做了研究,首次发现耳念珠菌的菌丝形态,同时,多细胞聚集形态比单细胞形态下的耳念珠菌耐药性更强;他还建立了一种新的毒性检测模型,通过大蜡螟和小鼠的感染模型实验看出,耳念珠菌的毒力远低于另一种常见病原真菌白念珠菌。
此后,中国医科大学附属第一医院检验科主任尚红及其团队鉴定出15名住院患者感染了耳念珠菌,中国人民解放军军事医学科学院在北京某医院新生儿重症监护室又鉴定出2例。“至此,中国大陆共确认18例耳念珠菌临床感染病例,我们还在持续监测。”廖万清表示,在广西、内蒙古、浙江、江苏、海南、广东、河北、陕西等很多个省区,他所在的院士工作站都在监测耳念珠菌的情况。
“从现有文献看,感染者大多会有原因不明的发高烧,各种药物治疗无效,并伴随各种器官衰竭、呼吸衰竭等表现。”廖万清介绍说。
“早产儿、低出生体重儿以及老年患者,由于自身免疫系统较弱而被认为是高危患者,死亡率极高。耳念珠菌感染患者一般都伴有其他严重的疾病,这进一步增加了病人的死亡风险。”贵州医科大学附属医院皮肤科医生黄倩等人在《“超级真菌”耳念珠菌研究进展》一文中总结了易感人群和环境特征。
耳念珠菌能够在干燥和潮湿的表面、床上用品、地板、水槽、空气、床上、皮肤、鼻腔和病人的内部组织等不同环境长时间存活,引发血液、肺部、尿道、表伤口感染以及耳道等部位的感染,对使用医疗辅助设备如尿管等内置导管、呼吸器械、长期住院,重症监护病房患者,或免疫系统疾病患者如艾滋病、糖尿病等,尤为危险。
此外,对耳念珠菌的鉴别存在一定困难,传统的生化鉴定方法很难鉴定超级真菌,目前主要使用质谱技术和分子生物学这两种方法。据第二军医大学长征医院皮肤科主治医师方文捷介绍,当病人出现不明原因发热且用药无效时,临床医生会让患者抽血检验是否有真菌感染。血样到检验科后,放在培养皿上培养,一段时间后,培养皿上会出现多个菌落,这时医生会选取一两个菌落做质谱分析或一代基因测序,以确认真菌种类。但由于仪器使用成本较高,不会将全部菌落都拿去分析,能否挑中超级真菌,则十分依赖检验医生的知识水平和经验。
“很有可能漏检”,多位受访对象都表达了这一观点。不仅在挑选菌落的环节容易出现漏检,在后续分析阶段,很多医院还不具备质谱仪等先进检验设备。除大型三甲医院,肯花300多万元人民币买一台质谱仪的医院在中国并不普遍。
基因组分析已经证实了耳念珠菌有多个毒力因子编码基因。从基因角度分析,中国分离出的耳念珠菌与美国等地菌株的毒性差异并不大,“中国病例报道少,并不意味着中国境内的耳念珠菌感染或携带者很少。这可能是由于目前大多数医院的鉴定能力有限,不能分离和准确鉴定出耳念珠菌。”《“超级真菌”耳念珠菌研究进展》一文总结道。

2017年起,廖万清团队发表了数篇论文呼吁中国提高对耳念珠菌的重视和预防,其所在的院士工作站也一直在监测耳念珠菌的情况,遍布广西、内蒙古、浙江、江苏、海南、广东、河北、陕西等很多个省区。图/受访者提供
从何而来?
2016年6月24日,美国疾控中心发出警报,呼吁全美相关医疗机构高度警惕耳念珠菌感染,尽快建立相应防治策略,防止该菌扩散和侵袭性疾病的蔓延,并设立了官方电子邮件回答相关问题。据《纽约时报》报道,真菌研究小组成员原以为“每个月会收到一条消息”,没想到几周后,收件箱爆满。
五个月后,美国疾控中心官方网站通报,发现了“超级真菌”耳念珠菌,已经造成至少13人感染,4人死亡。与十年前首次发现耳念珠菌相比,人们对它的认知已经发生了巨大的转变。2009年,日本医生第一次在一名女患者的外耳道分泌物中发现耳念珠菌,但当时还没有发现它的致命性。
两年后,这个看似无害的真菌出现在韩国水原大学医学院检验科医生李伟桥(音译,Wee Gyo Lee)的研究中。他发现耳念珠菌引起了3名患者出现真菌性败血症,证明此种病原体能够引起侵袭性血行感染。另一位荷兰微生物学家杰克·梅斯也于2012年发现了类似的情况,他当时正在分析印度四家医院的18名患者的血液感染样本,在其中发现了这种真菌的身影。此后不久,世界各地似乎每个月都会出现耳念珠菌感染的报道。
“耳念珠菌的传播方式还不清晰,目前已知的是,英国一家医院的神经科重症监护病房出现的耳念珠菌感染,最可能的传播方式是腋窝体温计在重复使用后造成交叉感染。”黄广华介绍说,一旦人体携带耳念珠菌,皮肤、呼吸道等都可能是其入侵渠道,“对耳念珠菌的研究从2016年才开始明显增加,相关基础研究还比较浅,关于入侵途径,现在还没有一个确切的结论。”
美国疾控中心的研究人员原本猜测,耳念珠菌可能起源于亚洲,并传播到全球,但当对比来自印度、巴基斯坦、委内瑞拉、南非和日本的耳念珠菌样本基因时,却发现它们的起源并不在一个地方。《纽约时报》报道称:基因组测序显示,这种真菌存在四种不同版本,且彼此差异较大,以至于研究人员猜测,这些菌株在数千年前就已经分化,同时在四个不同的地方从无害的环境菌株中脱颖而出,成为耐药病原体。
韩国医生李伟桥通过对既往病历的回顾性检测,追溯到目前最早的感染病例,出现在1996年,由于当时检验水平有限等原因,耳念珠菌被误诊为另一种真菌“希木龙念珠菌”。这一结论在尚红团队得到了验证,通过对2016年4月至2017年10月期间该院15位住院患者临床标本的重新鉴定,原本被误诊为“希木龙念珠菌”的病例均为耳念珠菌感染。
杰克·梅斯对耐药真菌的出现提出了新的看法。他曾到美国疾控中心分享研究成果,认为是农作物大量使用杀菌剂导致了抗药性真菌的发展。廖万清则给出了另一种解释。“随着免疫抑制剂广泛应用于器官移植患者;侵入性检查或治疗的日益增多;广谱抗生素的滥用以及其他疾病如HIV感染、糖尿病等发病率的逐年上升,新的致病真菌不断出现。”
对此,廖万清解释说,虽然抗生素只针对细菌,但会造成菌群平衡失调,且随着抗真菌药物使用的增多,原本不耐药的真菌(如白念珠菌)被压制后,耐药的耳念珠菌就成了优势菌种,它对人体的破坏性也逐渐显现。
上海市医学真菌分子生物学重点实验室近年来多次发现并报道了既往非致病真菌首次引起人类感染的病例,如指甲隐球菌引起脑膜炎等。“现代医疗延长了患者寿命,使真菌感染的可能成为现实。同时,这样的感染可能原本就有,随着检验技术的提高,逐渐被科研人员发现。”廖万清解释说,“现有的有效抗真菌药物相对有限,由于真菌细胞与人体细胞类似,都是真核细胞,抗真菌药物的研发比抗细菌药物更难,因此临床医生在应用时应尽可能根据药敏结果选择药物,避免抗真菌药物的滥用,减少多重耐药真菌的出现。”
耳念珠菌的来源目前还不明确,是环境真菌还是人体共生菌,也不清楚。研究人员普遍认为,这是新近进化出来的、快速适应人体宿主环境能力的新物种,主要引起血液感染,死亡率高达60%。与耳念珠菌的神秘来源相比,阻断其传播的现实手段似乎更为迫切。
防御措施
美国疾控中心设有真菌部门,在其官网上,详细介绍了预防耳念珠菌的措施和指导性用药建议,并明确提出,如果医疗机构或实验室怀疑有耳念珠菌感染病例,应立即联系地方公共卫生机构和疾控中心,寻求指导。
家庭常用的消毒方法如开水消毒等,对耳念珠菌根本不起作用。不过,黄广华强调说,耳念珠菌对健康人不会造成太大影响,真菌感染主要发生医院内,集中在免疫力低下的人群,如ICU病房。美国的大规模流行也都是在院内发生的。
“我们一直在呼吁,警惕超级真菌的潜在威胁,早发现、早隔离、早治疗,”廖万清告诉《中国新闻周刊》,2017年起,廖万清团队发表了数篇文献呼吁对耳念珠菌的重视和预防。为应对这一新出现的公共卫生问题,4月9日上午,中国人民解放军第二军医大学附属长征医院专门举办了研讨会,黄广华应邀前来,向医生们介绍了耳念珠菌的最新研究进展。
黄广华本人也曾组织多位相关领域学者,与《菌物学报》合作,在2018年10月出了一期关于病原真菌的专刊。“真菌感染已成为全世界临床上面临的严重问题,是人类健康不容忽视的杀手,但中国对真菌感染的临床和基础研究明显落后于细菌和病毒感染领域,相关研究获得的资助也非常有限。”专刊的序文中写道。
全世界每年真菌引起的浅部感染人数超过3亿,在免疫缺陷人群中,真菌引起的致命性深部器官或血液感染达250万例以上,致死率超过50%。然而,公众和科研主管部门对病原真菌感染的认知却非常有限。多位检验科医生表示,临床医生对真菌感染的了解明显少于细菌和病毒感染,很多人至今还没听说过耳念珠菌的存在。
临床上如果不能及时发现、预防和控制耳念珠菌的感染和传播,导致爆发性流行,其后果难以想象。基于中国各级医院的现有条件,设计一种简单、低成本的检测技术,似乎是一种现实可行的考虑。
廖万清团队与荷兰皇家科学院联合开发了两套针对耳念珠菌的诊断方法,一是针对没有质谱仪的单位和国家,搭建一个只需几万元的检测平台;第二种方法是,跳过培养步骤,避免人为漏检,直接对抽血样本进行检测。目前,两项技术已经完成实验室验证,但是国内临床病例过少,暂时无法进行临床试验。
4月11日,国家卫健委抗菌药物临床应用与细菌耐药评价专家委员会办公室主任徐英春回应称,耳念珠菌在中国发生仍属个案,且耐药情况不严重,截至目前,我国尚未见耳念珠菌感染导致死亡的病例报道。
徐英春还表示,耳念珠菌流行具有地域性差异;该病原真菌在世界范围的出现,提醒在中国确实应该重视病原性真菌及其所致感染的防治;在进行监测和防控方面的工作时,一定要按照规范的方法对病原性真菌做出准确的菌种鉴定和药物敏感性测定。






公安备案号:32010202010067
我要说两句